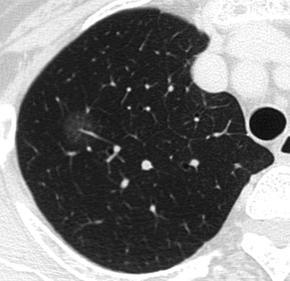

2020-06-19 23:01:57 sunmedia 2866
朋友們在行肺部CT檢查時,有時會發(fā)現(xiàn)一些小結(jié)節(jié),往往會緊張得不行。最主要是擔心這些小結(jié)節(jié)會不會是早期肺癌。一般來說,直徑小于1厘米的結(jié)節(jié)癌變的可能性比較小。但是這時小結(jié)節(jié)的形態(tài)、大小、周圍比鄰關(guān)系等等,與是否癌變的關(guān)系比較大。其中,比較重要的是一種叫做磨玻璃樣肺部結(jié)節(jié)的形態(tài)。肺磨玻璃樣結(jié)節(jié)(G)是磨玻璃樣改變的簡稱。在肺部CT影像上表現(xiàn)為密度輕微增加,增加程度小于實性改變,呈模糊的云霧狀,并可見其內(nèi)血管和支氣管紋理。
根據(jù)肺部磨玻璃影內(nèi)部成分均一程度的不同,G又可分為單純磨玻璃影(pG)及混合型磨玻璃影(mG)。G病變的鑒別范圍包括感染性病變、腫瘤等多方面。由于早期腫瘤也可表現(xiàn)為G,因此針對G病變予以單純手術(shù)切除后,可以達到腫瘤長期治愈的效果,5年生存率幾乎100%。而且,如果病理分期為I期的話,還免去了術(shù)后輔助治療。因此,在臨床上加強對于G病變的隨訪是有重要意義的。既然判斷G良惡性這么重要,我們該如何采取隨訪呢?
首先,對于G病變首先需結(jié)合臨床分析?;颊邽橹欣夏耆?,長期吸煙史,患癌的幾率更高些,更應該足夠重視。其次,結(jié)合G 病變的影像學特征,看它符合腫瘤影像的特點有哪些,比較常見的惡性影像學特征包括:分葉、短毛刺,胸膜凹陷及牽拉征,如果行高分辨CT檢查,可以發(fā)現(xiàn)向腫瘤供血的血管。再次,G隨訪的頻率是與結(jié)節(jié)灶的大小、是否具備有患癌的高危因素有關(guān)。
對于沒有吸煙史、一級親屬患癌史,及石棉暴露的低?;颊撸?/p>
結(jié)節(jié)<6 mm時,可不必常規(guī)隨訪。
結(jié)節(jié)在68 mm之間時,建議每612個月定期隨訪,病情穩(wěn)定后延長至每1824個月一次。
結(jié)節(jié)>8 mm時,每3個月隨訪一次,可考慮PET/CT或活檢。
而對于中老年人、長期吸煙史等高危因素的高?;颊撸?/p>
結(jié)節(jié)<6 mm時,即需要每12個月定期隨訪直至病情穩(wěn)定。
結(jié)節(jié)>6 mm時,隨訪頻率與低?;颊咭恢隆?/p>
對于高危的G患者,一旦快速長大,形態(tài)高度懷疑癌變,若大于1厘米且為實性結(jié)節(jié)者,可以考慮穿刺活檢,明確診斷。快速增大直徑大于1厘米但是為單純混合性磨玻璃樣結(jié)節(jié),宜行手術(shù)切除。大多數(shù)病人可推薦胸腔鏡微創(chuàng)切除,以絕后患。
這些術(shù)后病人,是否需要術(shù)后輔助化療治療?
一般來說,該類病人術(shù)后的病理分期為T1N0M0 IA期。無論是依據(jù)NCCN指南還是中國版的肺癌指南,這個病例都是不需要術(shù)后輔助治療的。所以,早期手術(shù)切除的病人達到根治的目標。
錢遠宇 主任醫(yī)師 中國人民解放軍總醫(yī)院(301醫(yī)院) 腫瘤內(nèi)科
本文是錢遠宇醫(yī)生原創(chuàng)作品,未經(jīng)授權(quán)請勿轉(zhuǎn)載。